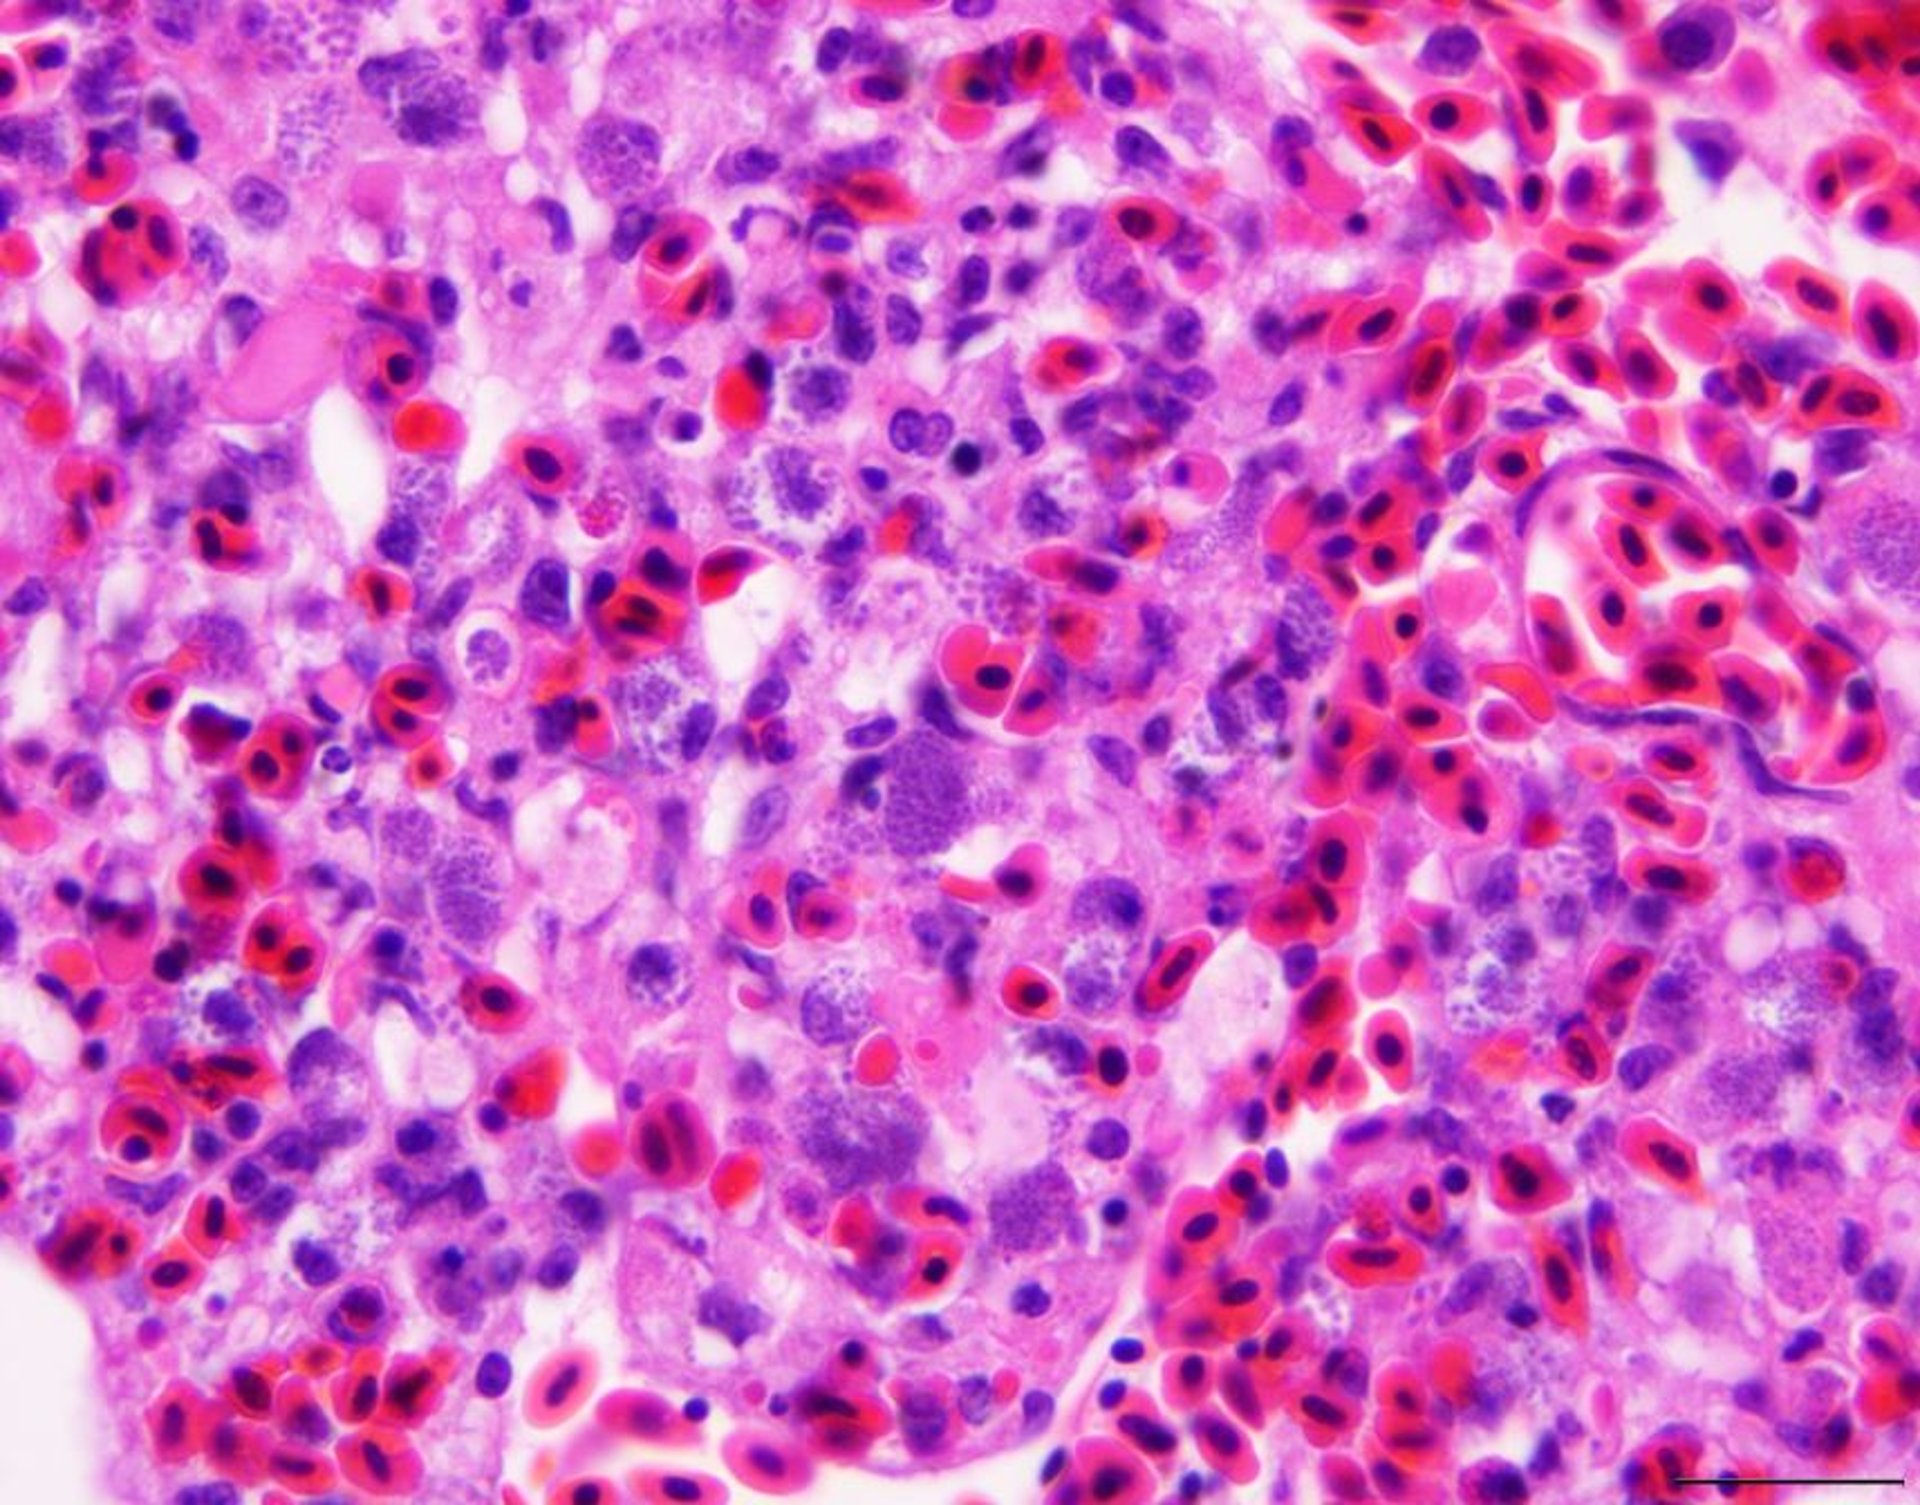
<i >Leucocytozoon</i>, photomicrograph, lung, Muscovy duck

Leucocytozoon, photomicrograph, lung, Muscovy duck
Photomicrograph showing Leucocytozoon schizonts containing merozoites in numerous pulmonary endothelial cells of a Muscovy duck (Cairina moschata). H&E stain; scale bar = 20 mcm.
Courtesy of Dr. A. J. Van Wettere.
In these topics